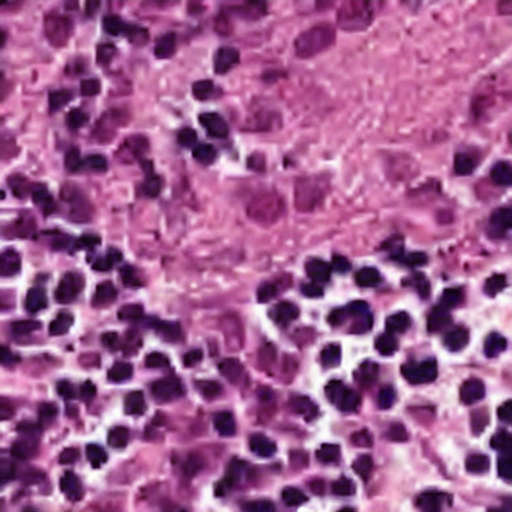
img_1

DreamBooth - anic87/pcam_normal_tumor
This is a dreambooth model derived from anic87/pcam_normal. The weights were trained on a photo of sks metastatic-lymph-node-tissue using DreamBooth. You can find some example images in the following.
DreamBooth for the text encoder was enabled: False.
- Downloads last month
- 1
Model tree for anic87/pcam_normal_tumor
Base model
anic87/pcam_normal